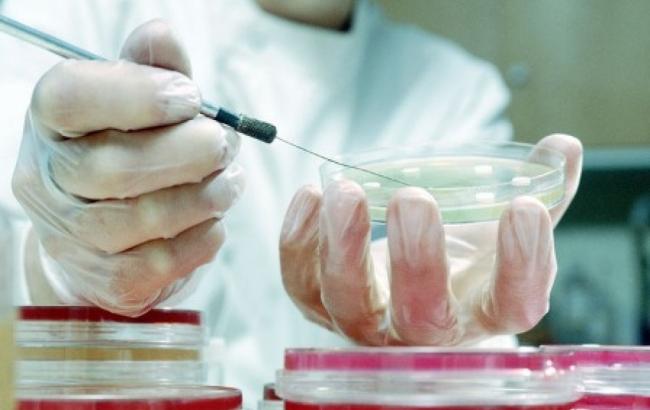
first_image

В США от неизвестной инфекции умерли 18 человек
18.03.16 - 17:36 Специалисты департамента здравоохранения штата Мичиган (США) официально подтвердили факт смерти человека после заражения неизвестной кровяной инфекцией. Он стал уже 18 жертвой инфекции. Об этом сообщает The Washington Post.
Специалисты департамента здравоохранения штата Мичиган (США) официально подтвердили факт смерти человека после заражения неизвестной кровяной инфекцией. Он стал уже 18 жертвой инфекции. Об этом сообщает The Washington Post.
По данным издания, Мичиган стал вторым штатом, на территории которого зарегистрирована смерть от заболевания.
Чуть ранее вспышка инфекции была зафиксирована в Висконсине. Там заболевание носит более масштабный характер, оно уже унесло 17 жизней. А общее количество зараженных на данный момент превысило 50 человек.
Первый летальный случай в штате был зарегистрирован в ноябре прошлого года. Медики пока не определили причину.
Известно, что бактерии Elizabethkingia распространяются в воде и почве. Однако они не вызывают заражения организма и не передаются при контакте с инфицированным человеком. По одной из версий, инфекция могла поразить пациентов через медоборудование, например, через трубки для кормления или зонды.
В национальном Центре по контролю и профилактике заболеваний считают, что не обошлось без "генетического отличительного признака".
Напомним, 11 марта в Гондурасе официально подтвержден первый случай гибели от синдрома Гийена-Барре (СГБ), который считается одним из осложнений лихорадки Зика.
